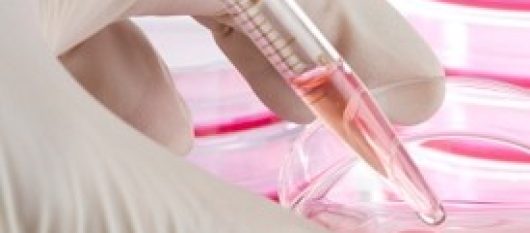
news-image

Utilizziamo i cookie e tecnologie simili di tracciamento per fornirti un servizio personalizzato rispetto alle tue esigenze di navigazione e per analizzare il nostro traffico. Raccogliamo e condividiamo con i nostri
1624 partner che si occupano di analisi dei dati web, pubblicità e social media, alcune informazioni sul tuo dispositivo, come l’indirizzo IP e le caratteristiche del tuo dispositivo, i quali potrebbero combinarle con altre informazioni che hai fornito loro o che hanno raccolto dal tuo utilizzo dei loro servizi. Puoi acconsentire all’uso di tali tecnologie cliccando il pulsante
“Accetta tutti” presente su questo banner oppure personalizzare le tue scelte, anche eventualmente negando il consenso al trattamento dei dati personali da parte dei partner terzi, cliccando sul pulsante
“Personalizza”.
Chiudendo questo banner (cliccando sul pulsante
“X” in alto a destra), acconsenti al permanere delle impostazioni predefinite che non consentono l’utilizzo di cookie o altri strumenti di tracciamento diversi dai tecnici.
Noi e i nostri partner trattiamo i tuoi dati di navigazione per: Archiviare informazioni su dispositivo e/o accedervi. Utilizzare dati limitati per la selezione della pubblicità. Creare profili per la pubblicità personalizzata. Utilizzare profili per la selezione di pubblicità personalizzata. Creare profili per la personalizzazione dei contenuti. Utilizzare profili per la selezione di contenuti personalizzati. Misurare le prestazioni degli annunci. Misurare le prestazioni dei contenuti. Comprendere il pubblico attraverso statistiche o la combinazione di dati provenienti da fonti diverse. Sviluppare e migliorare i servizi. Utilizzare dati limitati per la selezione dei contenuti.
Per conoscere nel dettaglio quali cookie utilizziamo sul sito e per modificare, in qualsiasi momento, le tue preferenze, ti invitiamo a consultare la nostra
Cookie Policy.